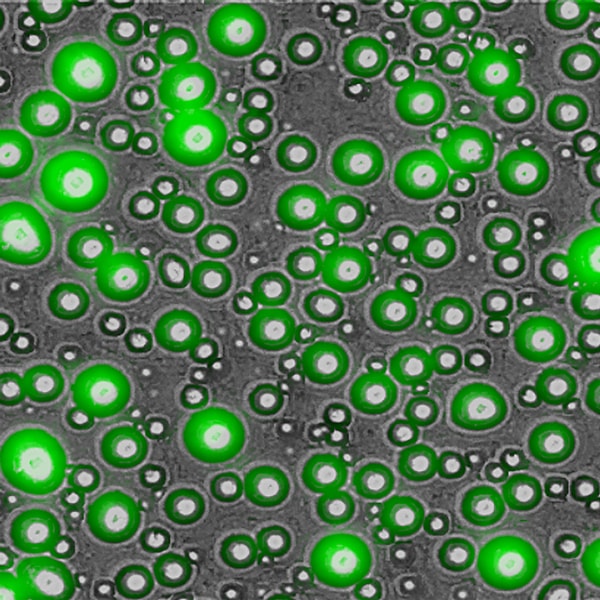

Image Gallery
Agilent BioTek imaging products are designed for a wide range of applications. Our customers are using the Lionheart Automated Microscopes, and Cytation Cell Imaging Multi-Mode Readers for their own unique research and in the process acquire beautiful, publication quality images and movies. Take a look at images captured with Agilent BioTek instruments.